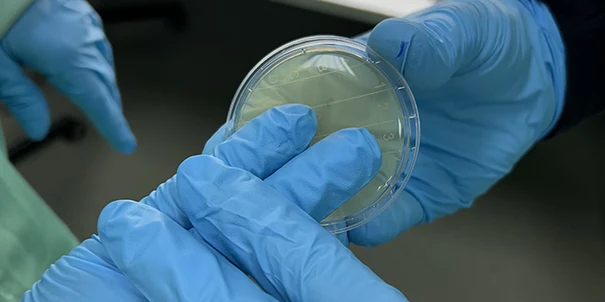
Control microbiológico de la Sala Blanca

Reinraum
Unser Reinraum ist mit 6 Spritzgießmaschinen bis zu 160 Tonnen, einer Siebdruckmaschine zur Dekoration von Dosierspritzen und Vaginalapplikatoren sowie einer Flowpack-Verpackungsmaschine mit PP-Folie ausgestattet.
Neben der Herstellung und Dekoration der Teile verfügen wir außerdem über einen Montage- und Handhabungsbereich für Medizinprodukte.
Umweltkontrolle des ISO-7-Reinraums
Das Vorhandensein eines Überdrucks innerhalb des Produktionsbereichs in Richtung der Schleusen (Material-SAS und Personal-SAS) sowie dieser Bereiche gegenüber der Außenumgebung verhindert das Eindringen von Luft, die nicht durch das Ultrafiltrationssystem geführt wurde.
Das Zugangsprotokoll für das Personal zum Produktionsbereich umfasst die Verwendung von Kleidung aus speziellen Materialien, die zu einer geringen Partikelemission beitragen.
Unser Reinraum verfügt über die Umweltqualifikation ISO 7/Klasse C gemäß dem Validierungsprotokoll, das jährlich in Übereinstimmung mit der Norm ISO 14698 durchgeführt wird.

Mikrobiologische Kontrolle des Reinraums
Dies stellt sicher, dass das Filtersystem korrekt funktioniert und die Produktionsumgebung sicher ist.

Reinigungs- und Desinfektionsprotokoll für den Reinraum
Die Desinfektion der Arbeitsflächen wird durch mikrobiologische Kulturen validiert, die mittels Probenahme mit Kontaktplatten durchgeführt werden.

Hochqualifiziertes Personal
Alle Mitarbeitenden von Triana sind in kontinuierliche Schulungsprogramme eingebunden. Auf diese Weise schließen wir durch Maßnahmen an den verschiedenen kritischen Punkten des Prozesses, basierend auf der durchgeführten Risikoanalyse und -bewertung, den Qualitätssicherungskreislauf des hergestellten Produkts.
Designed and made in Barcelona

